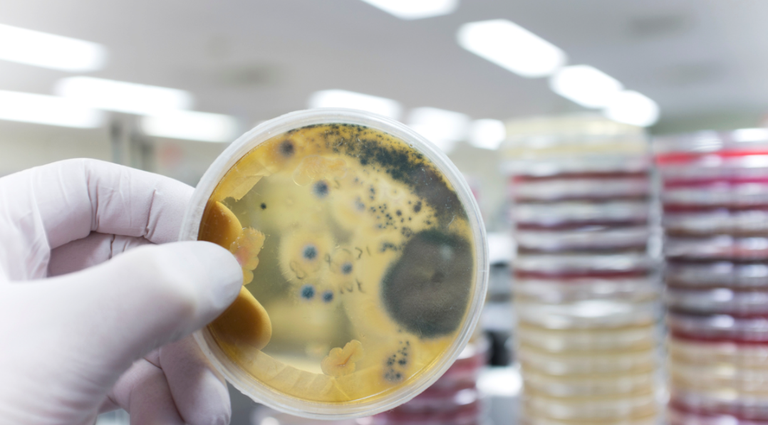
140 egunetan plastikoa deskonposatzeko gai den onddoa aurkitu dute

140 egunetan plastikoa deskonposatzeko gai den onddoa aurkitu dute
Sidney-ko Unibertsitateko zientzialari taldeak plastikoa deskonposatzen duen onddoa aurkitu du, baita degradatzeko izugarri zailak diren plastiko horiek ere. Guztia 140 egunetan bakarrik gainera! Plastiko mota batzuk birziklatzea zaila denez, aurkikuntza hau sekulako iraultza da.
Ikertzaileek, lurrean zein landareetan normalean aurkitu ohi diren bi onddo mota erabilita plastikoa degradatu zitekeela ondorioztatu zuten esperimentu baten bitartez. Aspergillus terreus eta Enguondontium album deitzen dira onddo hauek.
Albiste baikorra da honakoa. Izan ere, 2022ko Greenpeace-n txosten batek dio Estatu batuetan birziklatzen den plastikorik gehienak ozeano edo zabortegietan amaitzen duela, eta, ondorioz, airera gas kutsakorrak bota. Birziklatutako plastikoaren %5 bakarrik bihurtu zen artikulu berri.
Lisa Ramsden-ek, Estatu Batuetako Greenpeace-ko aktibistak, adierazi du 2050. urterako industriek plastikoaren ekoizpena hirukoiztu lezaketela, arazoa larriagotuz.
Sidney-ko ikertzaileek honen irtenbidea izan lezakete onddo hauei esker. Orain zeregina ahalik eta eraginkorrena bihurtzea da, merkatuan erabili ahal izateko. Ikerketak 3-5 urte iraun litzake. Bitartean, birziklatu beharrean ahalik eta plastiko gutxien erabiltzea guztion ardura da, arazoak ezin baitu horrenbeste itxaron eta teknologia irtenbidearen erdia baino ez baita.






